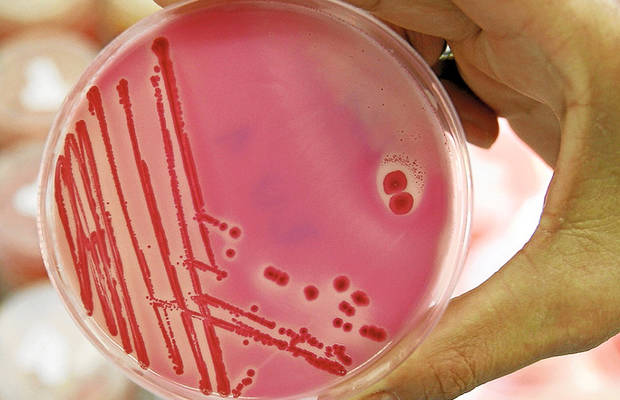

Nueve niños, afectados por una intoxicación alimentaria en un campamento en Málaga
Un total de nueve menores de edad han sufrido durante la madrugada de este domingo una posible intoxicación alimentaria en un campamento de verano en La Viñuela (Málaga).
Según han informado a Europa Press desde el servicio de Emergencias 112 Andalucía, sobre las 01.20 recibieron un aviso de que había varios menores con dolor abdominal y vómitos en el mencionado lugar.
Siete de estos nueve menores afectados tuvieron que ser trasladados al Hospital Comarcal de la Axarquía, según los sanitarios, aunque “ninguno está grave” y todos han regresado al campamento de nuevo, han asegurado desde el 112.
En el campamento, localizado en la urbanización Viñas del Lago de dicho municipio, hay unos 70 niños de entre once y catorce años, aunque solo se han visto afectado nueve de ellos. Debido a lo sucedido, se ha abierto una investigación para tratar de aclarar las circunstancias de los hechos.